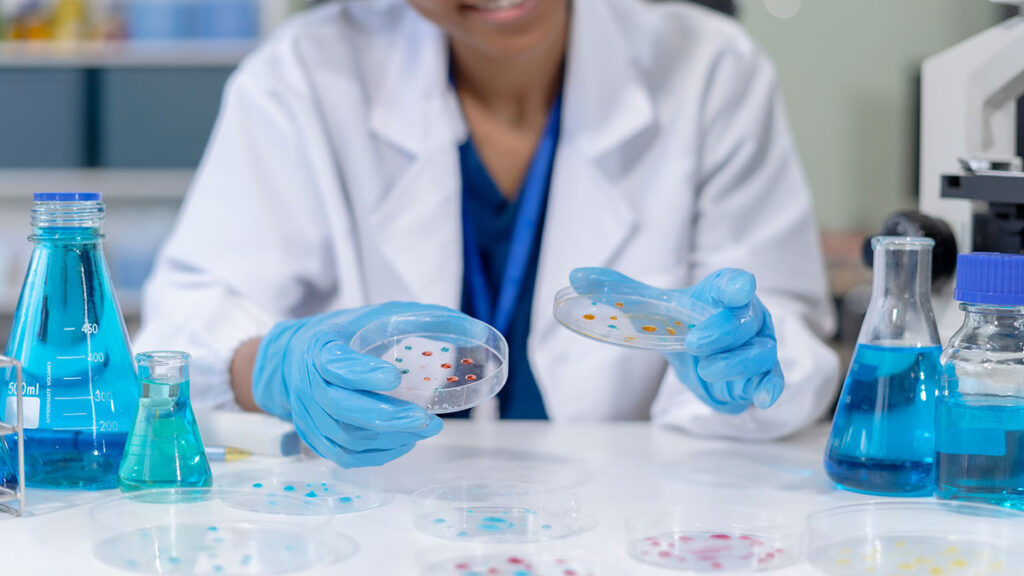

La donostiarra Quimatryx se alía con un grupo chino para su fármaco contra el cáncer. El Diario Vasco.

El acuerdo, valorado en 92 millones, acelerará el desarrollo del compuesto, que ya ha demostrado eficacia en tumores como el linfático o de páncreas, y la esclerosis múltiple. Gran parte de las investigaciones para el tratamiento del cáncer se dirigen en los últimos años a superar los métodos tradicionales de ataque a gran escala (quimioterapia, […]
Onena Medicines ha recibido el premio a la mejor empresa de biotecnología emergente Europea otorgado por MERCK Group.

Este premio ha sido otorgado durante la celebración se las semifinales del programa EIT Health Catapult donde MERCK actúa como uno de los patrocinadores de este programa. Los participantes del programa EIT Health Catapult pasan por 3 rondas de selección en el transcurso de un año, recibiendo capacitación y tutoría en el camino. El programa […]
Las biociencias, en auge en Gipuzkoa. El Diario Vasco
Biozientziak Fundazioa, Diputación y Kutxa Fundazioa reunieron a representantes de empresas del sector El espacio Etorkizuna Eraikiz Gunea de la Diputación Foral reunió en un encuentro de trabajo a los representantes de la Fundación Biozientziak Gipuzkoa, Diputación y Kutxa Fundazioa y los y las responsables de las empresas apoyadas por la Fundación. Esta entidad fue […]
Apoyo a tecnologías quirúrgicas, fármacos anticancerígenos y test de detección de alergias ‘made in Gipuzkoa’

La fundación Biozientziak Fundazioa impulsará tres nuevas iniciativas empresariales del territorio en el campo de las biociencias, tres start up que se dedican al desarrollo de técnicas quirúrgicas innovadoras, fármacos anticancerígenos y test de detección de alergias, entre otros. Las start up guipuzcoanas Deneb Medical, Innoprick y Quimatryx recibirán el apoyo de la fundación para […]